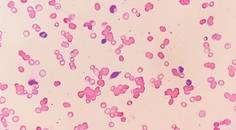
Retinal Imaging in Hematologic Disorders
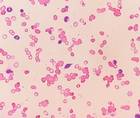
Retinal Imaging in Hematologic Disorders

Imaging/Diagnostics
2
1-16 of 34
- Glaucoma
Rationalizing the Red: When RNFL Atrophy Is Not Glaucoma
Katherine Rachon, OD, FAAO, Dipl ABOKatherine Rachon, OD, FAAO, Dipl ABO - Neuro-Optometry
Horner Syndrome Secondary to Bullet Fragments
Christopher J. Borgman, OD, FAAO; Catherine Hogan, OD, FAAOChristopher J. Borgman, OD, FAAO; Catherine Hogan, OD, FAAO - Imaging/Diagnostics
An Issue of Abundance
Walter O. Whitley, OD, MBA, FAAO; Selina R. McGee, OD, FAAOWalter O. Whitley, OD, MBA, FAAO; Selina R. McGee, OD, FAAO
- Prev
- Next